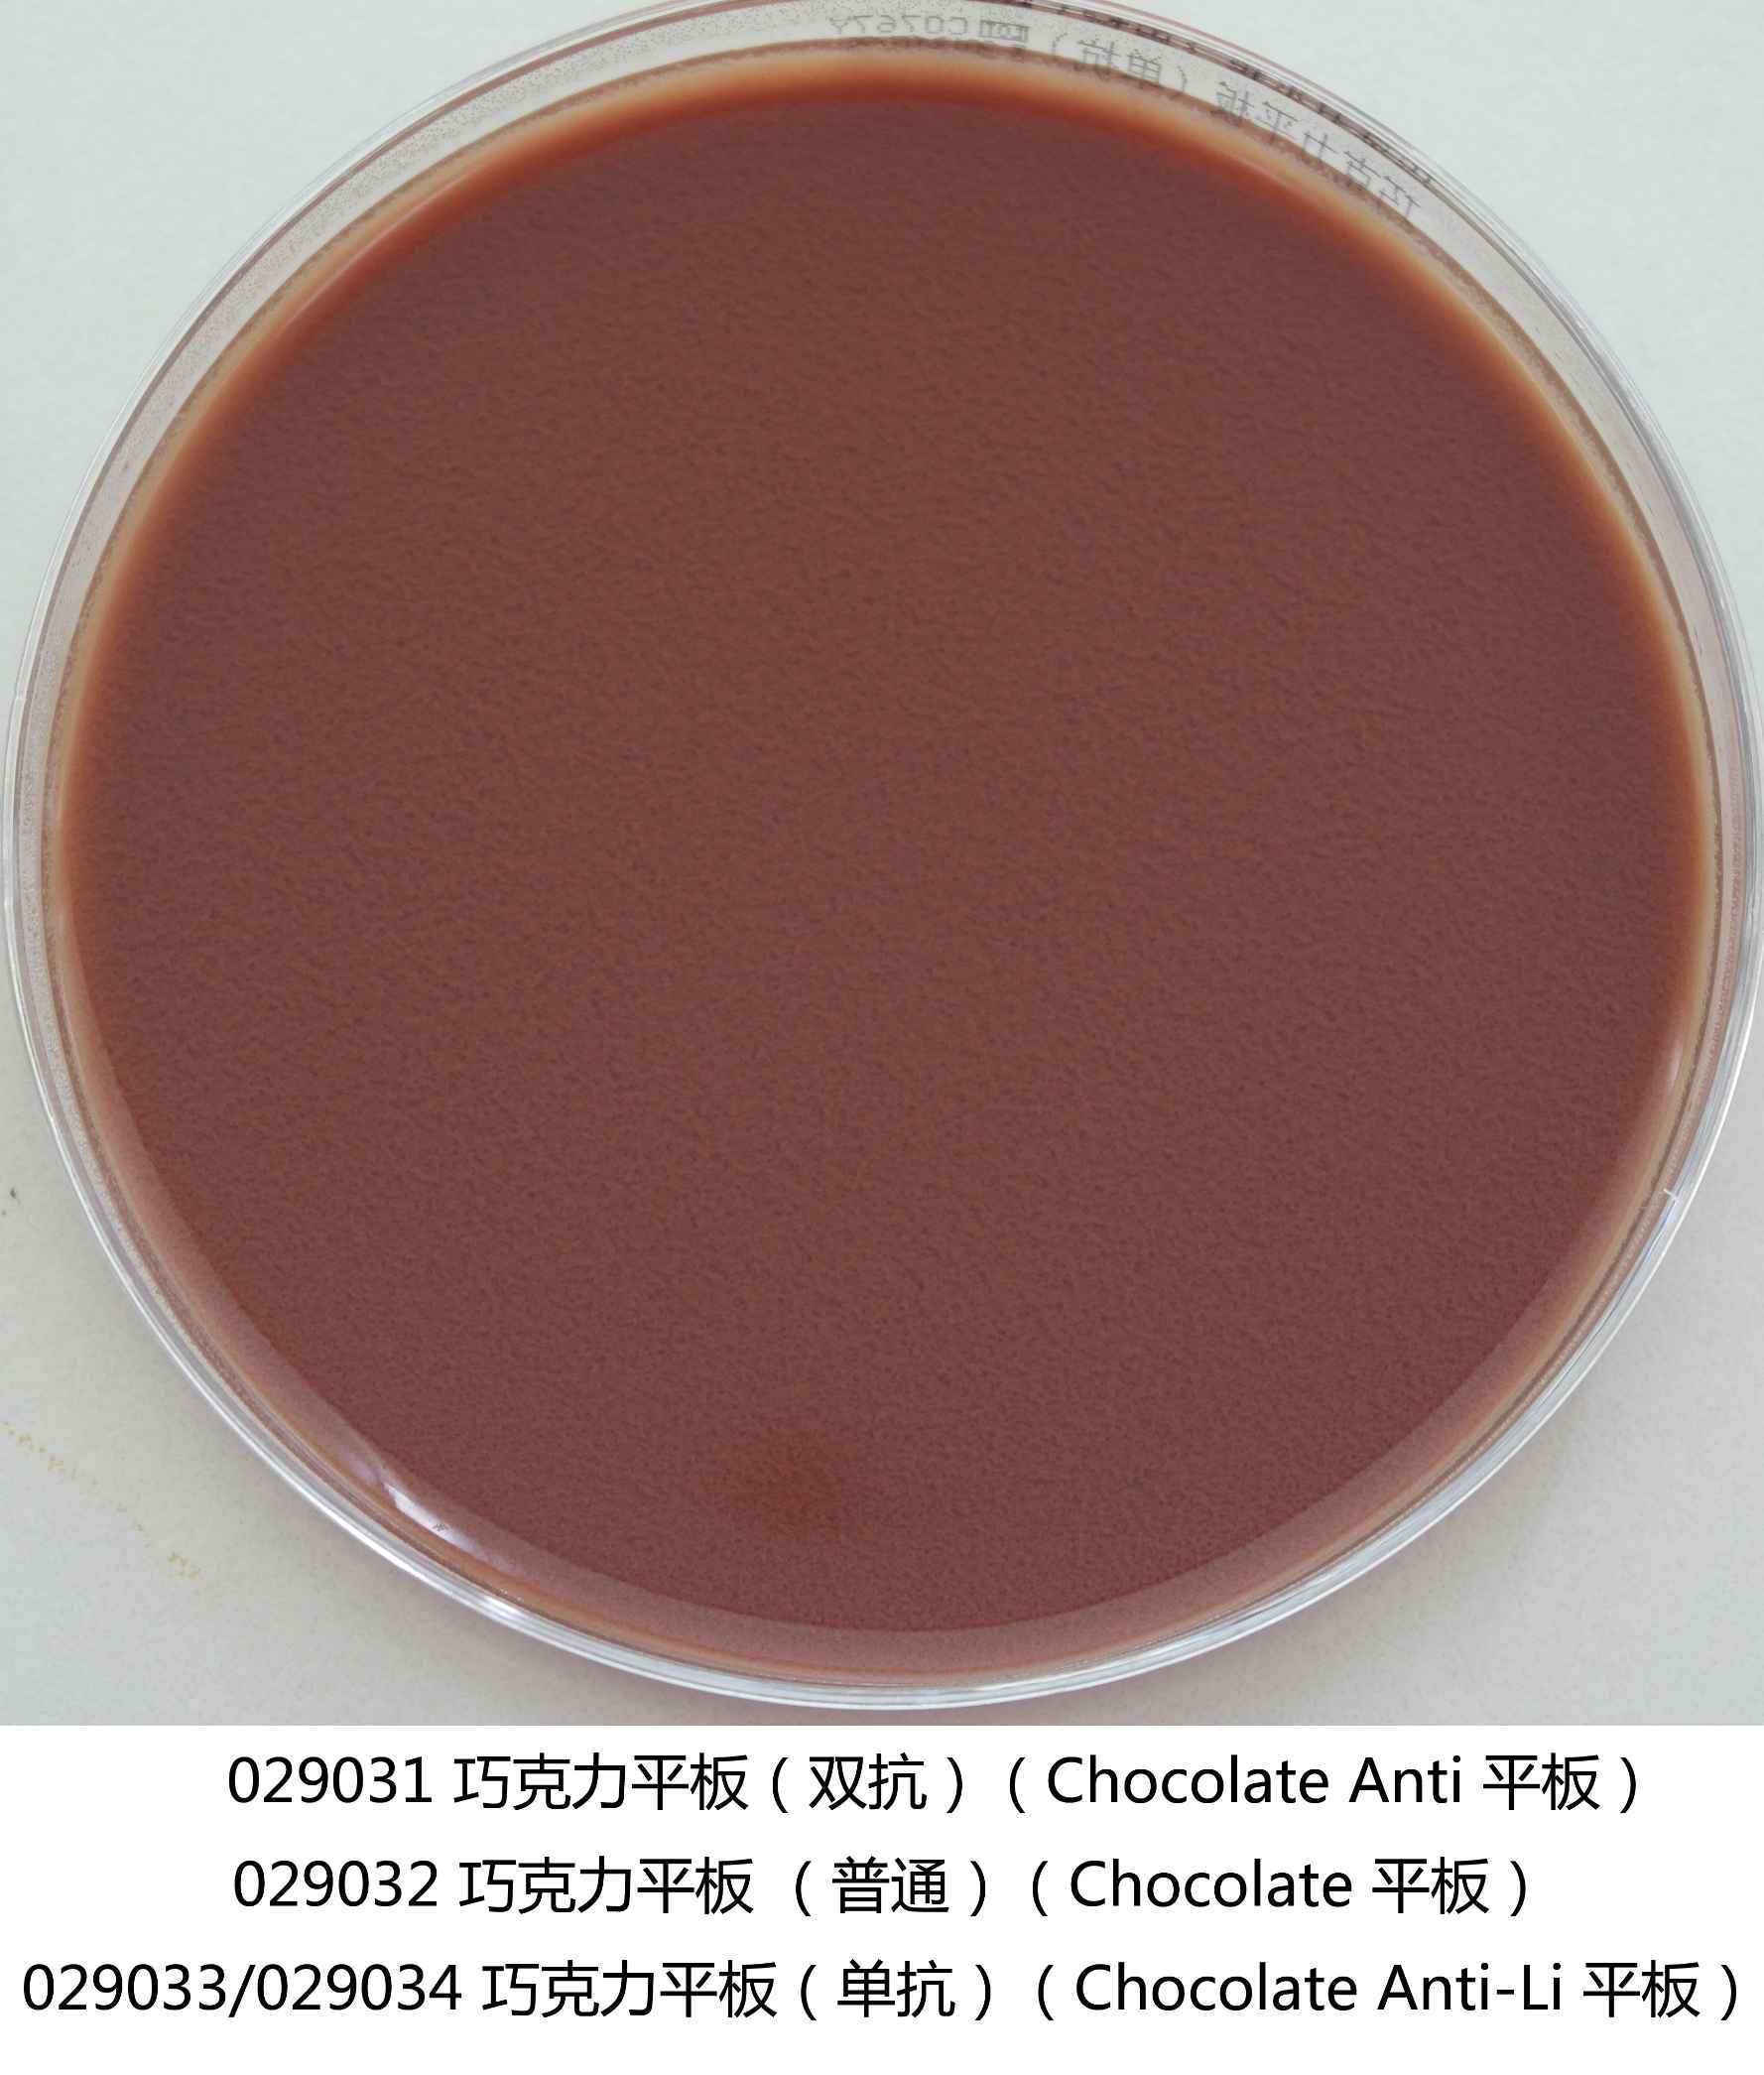

产品展示PRODUCTS
产品名称:巧克力平板培养基(双抗)
英文名称:Bi-Antibiot事話ic Chocolate Ag相白ar Plate
产品编号与包装规格:
| 产品编号 | 产品类型 | 包装规格 |
| 029031 | 即用型成(chéng)品平板 | 90mm×20个/盒 |
产品用途:用于细菌的培养,特别用于病原性奈瑟氏球菌的員些培养。
检验原理:各種(zhǒng)消化物和酵母浸出粉提供碳氮源、维銀校生素和生長(cháng)因子;淀粉能(néng志廠)促進(jìn)奈瑟氏菌的生長(cháng);氯化钠维持均衡的渗得事透压;多粘菌素、万古霉素抑制了革兰氏阳性菌的生長(cháng開站),更有利于奈瑟氏菌的生長(cháng);琼脂是培养笑市基的凝固剂;脱纤维羊血为苛养菌提供生長(chán上門g)因子。
配方成(chéng)分:
| 配方(每升) | 含量 |
| 多价胨 | 18.0g |
| 淀粉 | 1.0g |
| 氯化钠 | 5.0g |
| 多粘菌素-B | 4.2mg |
| 万古霉素 | 3.3mg |
| 琼脂 | 15.0g |
| 脱纤维羊血 | 40mL |
| 蒸馏水 | 1000mL |
| 最终pH 7.4&p友秒lusmn;0.2 | |
使用方法:拆包即可使用。
质量控制:下列质控菌株接種(zhǒng)後(hòu)置紙很于CO2培养罐36±1℃培养24h,观察结果如下表:
| 指标 | 质控菌株及编号 | 标准值 | 特征性反应 |
| 生長(cháng)率 | 脑膜炎奈瑟氏菌ATCC13090 | G≥5 | 灰白色菌落- |
| 选择性 | 大肠埃希氏菌ATCC25922 | G≤1 | - |
| 金黄色葡萄球菌ATCC6538 | - |
储存条件与保质期:2-25℃避光保存,具体有效期看产品标签。公媽
注意事(shì)项:
 章街; 1、在洁净环境下進(jìn)行操作,避免培养基被(bèi)污北理染。
&n不街bsp; 2、质检报告可以登录环凯愛到微生物培养基网站, 打開(kāi)“质火村检报告"页面(miàn),输入产品批号下载資科。
废物处理:检测之後(hòu)带菌物品置于12坐國1℃下高压灭菌30分钟後(hòu)处理。
执行标准:Q/HKSJ 03-2011 广东环凯微生物科技有限公司企业标准員煙 普通微生物培养基







